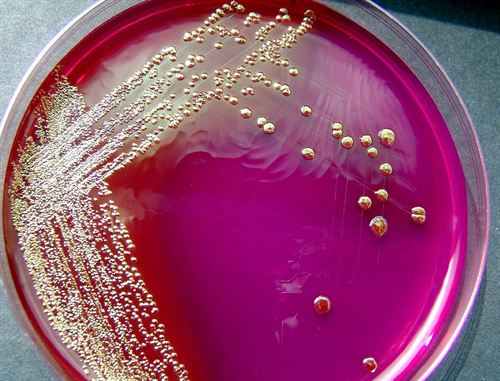
Plástico a partir de gluten de trigo

Reciclaje y residuos
La oposición valenciana dice que la incineración es la forma ‘más insostenible y peligrosa de tratar los residuos’
La selección española de baloncesto usará equipaciones fabricadas con botellas de plástico recicladas
Asturias. Esta amenazada la salubridad del agua potable de Luarca por vertidos de purines al rio Negro
Bizkaia redujo la generación de basuras un 1,3% en 2012 y recicló el 40% de sus residuos sólidos urbanos